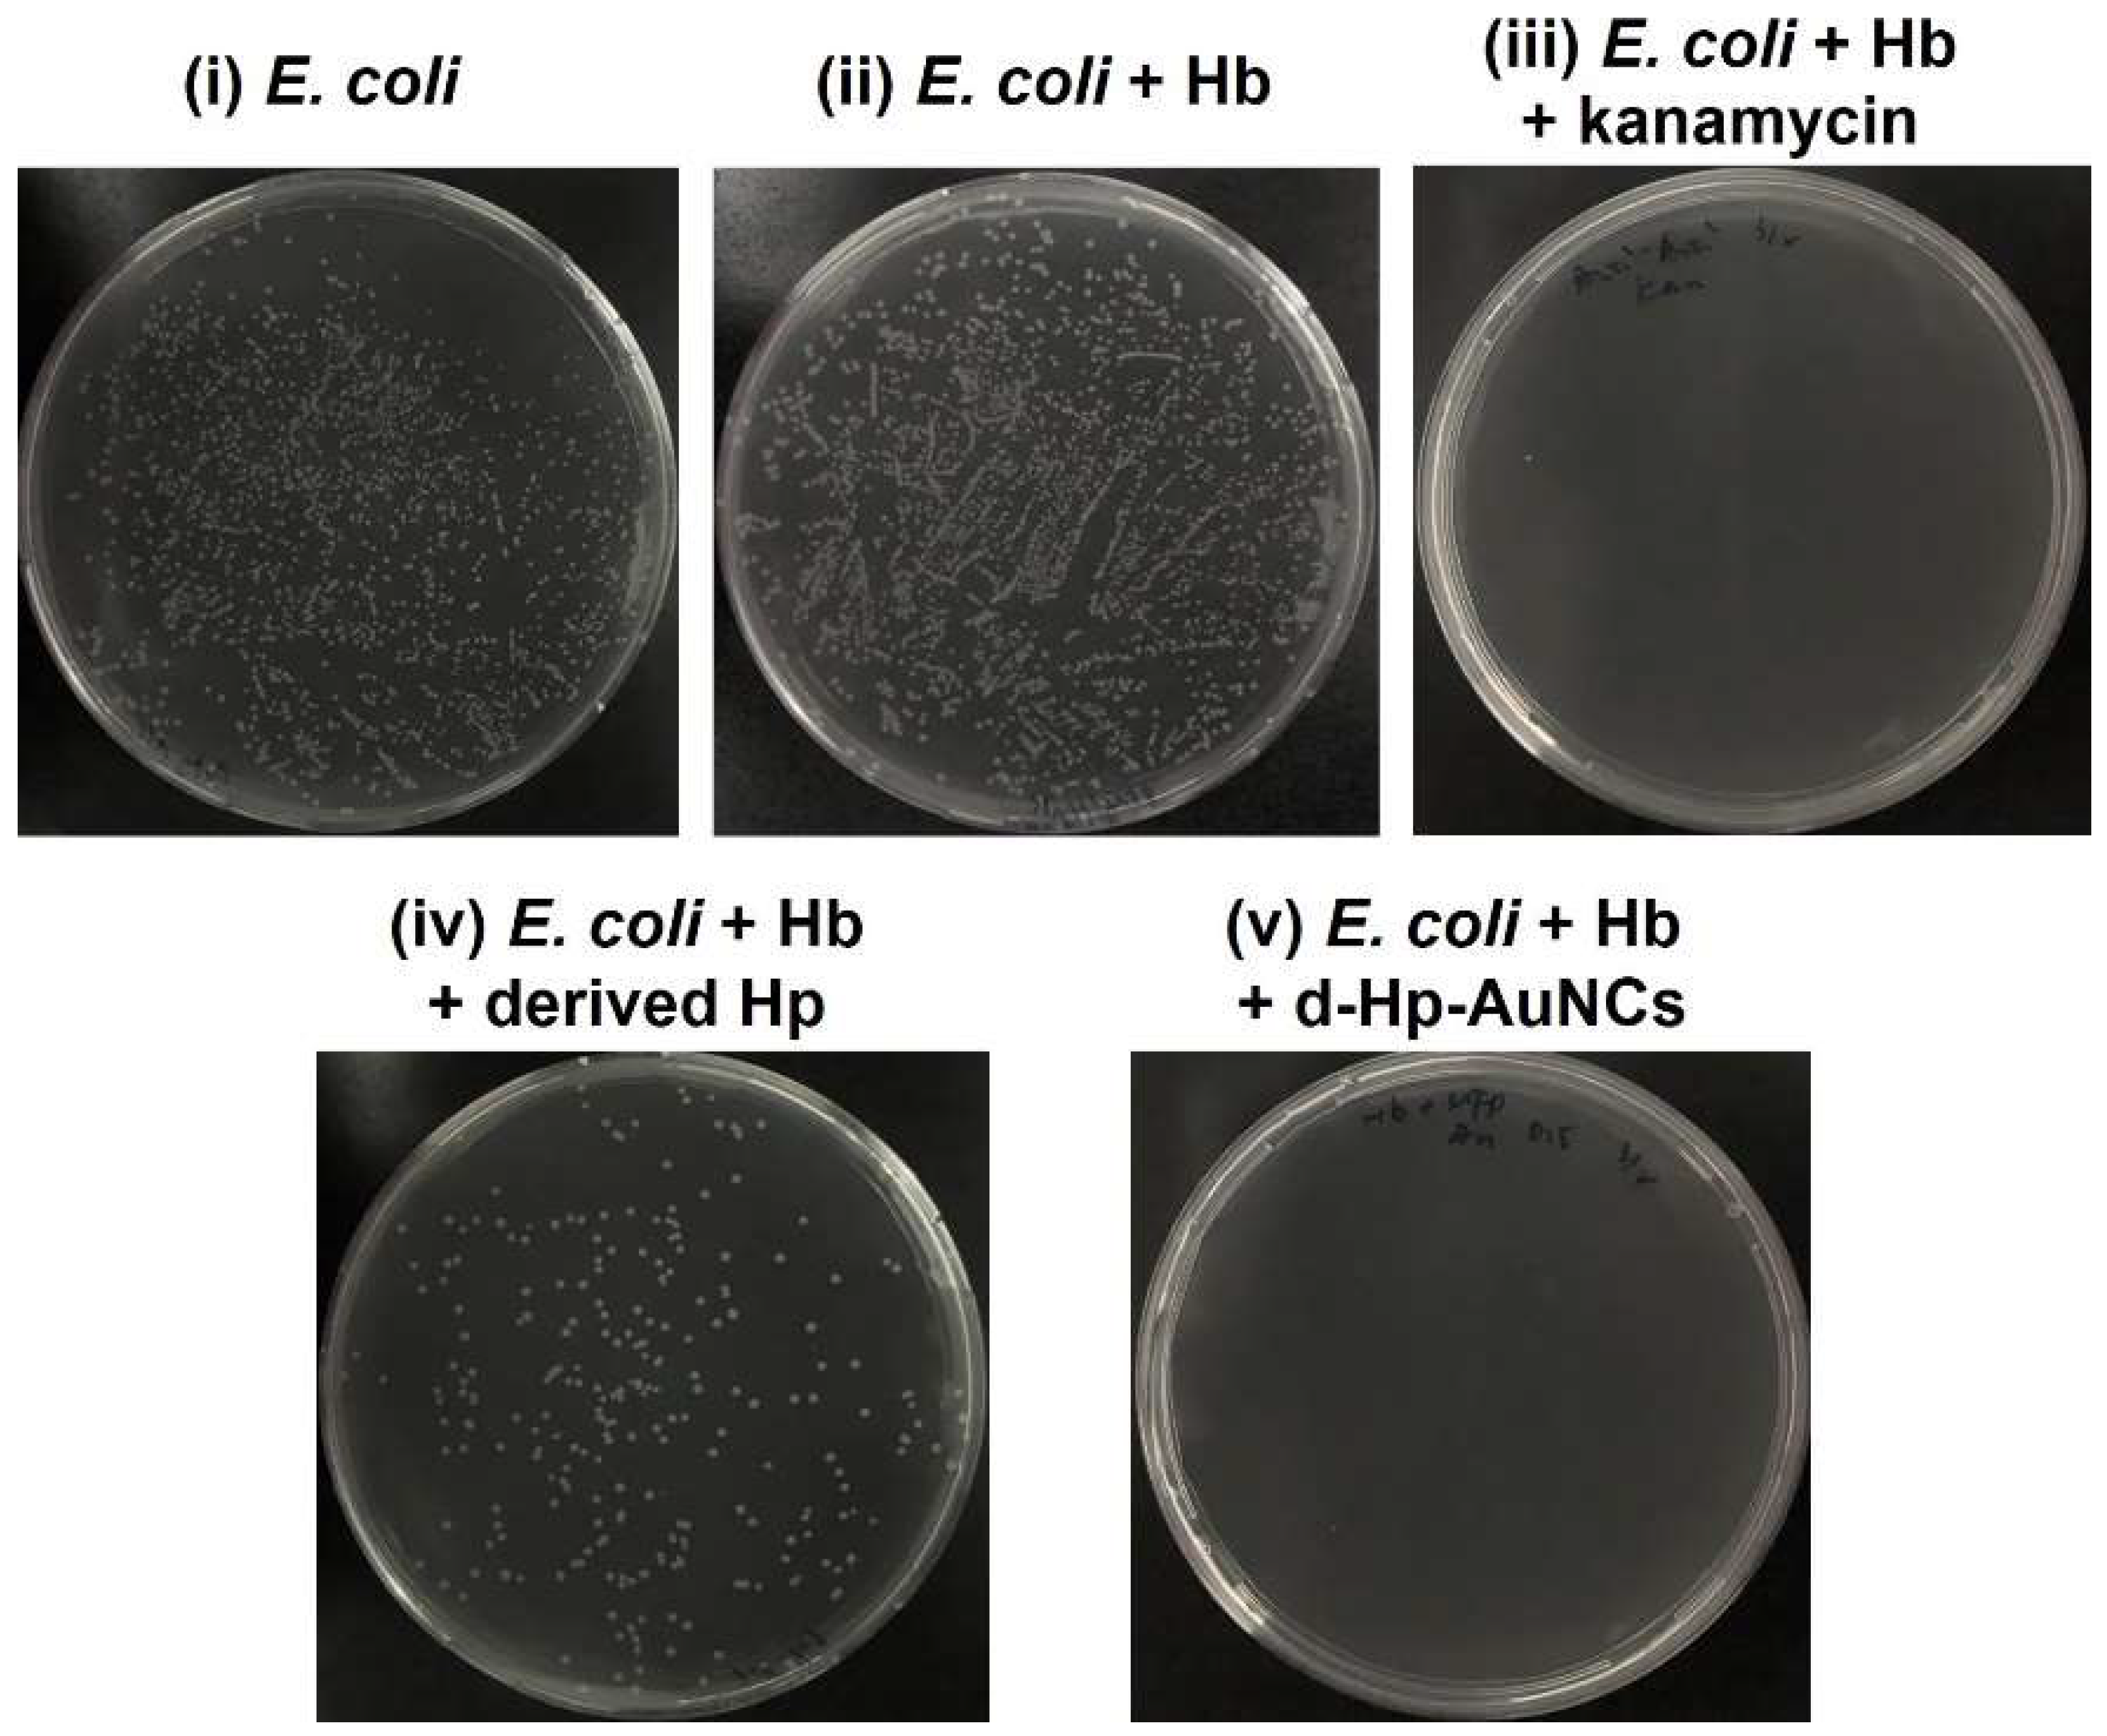
Nanomaterials 12 03596 g005

Haptoglobin-Conjugated Gold Nanoclusters as a Nanoantibiotic to Combat Bacteremia
Abstract
1. Introduction
2. Materials and Methods
2.1. Materials
2.2. Synthesis of D-Hp-AuNCs via a Facile Hydrothermal Approach
2.3. Expression of the Derived Hp Peptide
2.4. Purification of the Derived Hp Peptide
2.5. Bacterial Growth Curve and Agar Plate Counts
2.6. Evaluation of ROS Production
2.7. Statistical Analysis
3. Results and Discussion
3.1. Morphological Characteristics of D-Hp-AuNCs
3.2. Optical Properties of D-Hp-AuNCs
3.3. Antibacterial Activity of D-Hp-AuNCs
3.4. ROS Generation by D-Hp-AuNCs
4. Conclusions
Supplementary Materials
Author Contributions
Funding
Institutional Review Board Statement
Informed Consent Statement
Data Availability Statement
Acknowledgments
Conflicts of Interest
References
- Kadri, S.S.; Adjemian, J.; Lai, Y.L.; Spaulding, A.B.; Ricotta, E.; Prevots, D.R.; Palmore, T.N.; Rhee, C.; Klompas, M.; Dekker, J.P.; et al. Difficult-to-treat resistance in gram-negative bacteremia at 173 us hospitals: Retrospective cohort analysis of prevalence, predictors, and outcome of resistance to all first-line agents. Clin. Infect. Dis. 2018, 67, 1803–1814. [Google Scholar] [CrossRef]
- Kwong, T.N.Y.; Wang, X.S.; Nakatsu, G.; Chow, T.C.; Tipoe, T.; Dai, R.Z.W.; Tsoi, K.K.K.; Wong, M.C.S.; Tse, G.; Chan, M.T.V.; et al. Association between bacteremia from specific microbes and subsequent diagnosis of colorectal cancer. Gastroenterology 2018, 155, 383–390. [Google Scholar] [CrossRef]
- De Lorgeril, J.; Lucasson, A.; Petton, B.; Toulza, E.; Montagnani, C.; Clerissi, C.; Vidal-Dupiol, J.; Chaparro, C.; Galinier, R.; Escoubas, J.M.; et al. Immune-suppression by oshv-1 viral infection causes fatal bacteraemia in pacific oysters. Nat. Commun. 2018, 9, 4215. [Google Scholar] [CrossRef]
- Darton, T.C.; Zhou, L.Q.; Blohmke, C.J.; Jones, C.; Waddington, C.S.; Baker, S.; Pollard, A.J. Blood culture-pcr to optimise typhoid fever diagnosis after controlled human infection identifies frequent asymptomatic cases and evidence of primary bacteraemia. J. Infect. 2017, 74, 358–366. [Google Scholar] [CrossRef]
- Dagasso, G.; Conley, J.; Parfitt, E.; Pasquill, K.; Steele, L.; Laupland, K. Risk factors associated with bloodstream infections in end-stage renal disease patients: A population-based study. Infect. Dis. 2018, 50, 831–836. [Google Scholar] [CrossRef]
- Singer, M.; Deutschman, C.S.; Seymour, C.W.; Shankar-Hari, M.; Annane, D.; Bauer, M.; Bellomo, R.; Bernard, G.R.; Chiche, J.D.; Coopersmith, C.M.; et al. The third international consensus definitions for sepsis and septic shock (sepsis-3). JAMA-J. Am. Med. Assoc. 2016, 315, 801–810. [Google Scholar] [CrossRef]
- Butler-Laporte, G.; De L’Etoile-Morel, S.; Cheng, M.P.; McDonald, E.G.; Lee, T.C. Mrsa colonization status as a predictor of clinical infection: A systematic review and meta-analysis. J. Infect. 2018, 77, 489–495. [Google Scholar] [CrossRef]
- Jean, S.S.; Hsieh, T.C.; Ning, Y.Z.; Hsueh, P.R. Role of vancomycin in the treatment of bacteraemia and meningitis caused by elizabethkingia meningoseptica. Int. J. Antimicrob. Agents 2017, 50, 507–511. [Google Scholar] [CrossRef] [PubMed]
- Chou, D.W.; Wu, S.L.; Lee, C.T.; Tai, F.T.; Yu, W.L. Clinical characteristics, antimicrobial susceptibilities, and outcomes of patients with chryseobacterium indologenes bacteremia in an intensive care unit. Jpn. J. Infect. Dis. 2011, 64, 520–524. [Google Scholar] [CrossRef]
- Lee, H.C.; Chuang, Y.C.; Yu, W.L.; Lee, N.Y.; Chang, C.M.; Ko, N.Y.; Wang, L.R.; Ko, W.C. Clinical implications of hypermucoviscosity phenotype in klebsiella pneumoniae isolates: Association with invasive syndrome in patients with community-acquired bacteraemia. J. Intern. Med. 2006, 259, 606–614. [Google Scholar] [CrossRef]
- Jean, S.S.; Hsieh, T.C.; Hsu, C.W.; Lee, W.S.; Bai, K.J.; Lam, C. Comparison of the clinical efficacy between tigecycline plus extended-infusion imipenem and sulbactam plus imipenem against ventilator-associated pneumonia with pneumonic extensively drug-resistant acinetobacter baumannii bacteremia, and correlation of clinical efficacy with in vitro synergy tests. J. Microbiol. Immunol. Infect. 2016, 49, 924–933. [Google Scholar] [PubMed]
- Liu, C.T.; Chen, Y.C.; Chen, T.H.; Ou, T.Y. Necrotizing fasciitis of thigh associated with Escherichia coli bacteremia in a patient on chronic hemodialysis. Hemodial. Int. 2012, 16, 564–567. [Google Scholar] [CrossRef] [PubMed]
- Lee, W.S.; Chen, Y.C.; Chen, H.P.; Chen, T.H.; Cheng, C.Y. Vertebral osteomyelitis caused by vancomycin-tolerant methicillin-resistant staphylococcus aureus bacteremia: Experience with teicoplanin plus fosfomycin combination therapy. J. Microbiol. Immunol. Infect. 2016, 49, 600–603. [Google Scholar] [CrossRef]
- Teng, S.O.; Yen, M.Y.; Ou, T.Y.; Chen, F.L.; Yu, F.L.; Lee, W.S. Comparison of pneumonia- and non-pneumonia-related acinetobacter baumannii bacteremia: Impact on empiric therapy and antibiotic resistance. J. Microbiol. Immunol. Infect. 2015, 48, 525–530. [Google Scholar] [CrossRef] [PubMed]
- Tsai, C.C.; Hsu, C.C.; Chen, K.T. Incidence and clinical features of patients with peritoneal dialysis peritonitis complicated by bacteremia. Medicine 2018, 97, e13567. [Google Scholar] [CrossRef]
- Yu, W.L.; Lee, M.F.; Chen, C.C.; Tang, H.J.; Ho, C.H.; Chuang, Y.C. Impacts of hypervirulence determinants on clinical features and outcomes of bacteremia caused by extended-spectrum -lactamase-producing klebsiella pneumoniae. Microb. Drug Resist. 2017, 23, 376–383. [Google Scholar] [CrossRef]
- Kong, P.H.; Chiang, C.H.; Lin, T.C.; Kuo, S.C.; Li, C.F.; Hsiung, C.A.; Shiue, Y.L.; Chiou, H.Y.; Wu, L.C.; Tsou, H.H. Discrimination of methicillin-resistant staphylococcus aureus by maldi-tof mass spectrometry with machine learning techniques in patients with staphylococcus aureus bacteremia. Pathogens 2022, 11, 586. [Google Scholar] [CrossRef]
- Banik, A.; Bhat, S.H.; Kumar, A.; Palit, A.; Snehaa, K. Bloodstream infections and trends of antimicrobial sensitivity patterns at port blair. J. Lab. Physicians 2018, 10, 332–337. [Google Scholar] [CrossRef]
- Zhu, Y.P.; Kuo, T.R.; Li, Y.H.; Qi, M.Y.; Chen, G.; Wang, J.L.; Xu, Y.J.; Chen, H.M. Emerging dynamic structure of electrocatalysts unveiled by in situ X-ray diffraction/absorption spectroscopy. Energy Environ. Sci. 2021, 14, 1928–1958. [Google Scholar] [CrossRef]
- Tung, C.W.; Kuo, T.R.; Hsu, C.S.; Chuang, Y.; Chen, H.C.; Chang, C.K.; Chien, C.Y.; Lu, Y.J.; Chan, T.S.; Lee, J.F.; et al. Light-induced activation of adaptive junction for efficient solar-driven oxygen evolution: In situ unraveling the interfacial metal-silicon junction. Adv. Energy Mater. 2019, 9, 1901308. [Google Scholar] [CrossRef]
- Chang, Y.H.; Lin, J.C.; Chen, Y.C.; Kuo, T.R.; Wang, D.Y. Facile synthesis of two-dimensional ruddlesden-popper perovskite quantum dots with fine-tunable optical properties. Nanoscale Res. Lett. 2018, 13, 247. [Google Scholar] [CrossRef] [PubMed]
- Kuo, T.-R.; Liao, H.-J.; Chen, Y.-T.; Wei, C.-Y.; Chang, C.-C.; Chen, Y.-C.; Chang, Y.-H.; Lin, J.-C.; Lee, Y.-C.; Wen, C.-Y. Extended visible to near-infrared harvesting of earth-abundant FeS2-TiO2 heterostructures for highly active photocatalytic hydrogen evolution. Green Chem. 2018, 20, 1640–1647. [Google Scholar] [CrossRef]
- Kuo, T.R.; Chen, W.T.; Liao, H.J.; Yang, Y.H.; Yen, H.C.; Liao, T.W.; Wen, C.Y.; Lee, Y.C.; Chen, C.C.; Wang, D.Y. Improving hydrogen evolution activity of earth-abundant cobalt-doped iron pyrite catalysts by surface modification with phosphide. Small 2017, 13, 1603356. [Google Scholar] [CrossRef] [PubMed]
- Li, C.-H.; Kuo, T.-R.; Su, H.-J.; Lai, W.-Y.; Yang, P.-C.; Chen, J.-S.; Wang, D.-Y.; Wu, Y.-C.; Chen, C.-C. Fluorescence-guided probes of aptamer-targeted gold nanoparticles with computed tomography imaging accesses for in vivo tumor resection. Sci. Rep. 2015, 5, 15675. [Google Scholar] [CrossRef]
- Wang, J.; Tan, H.-Y.; Kuo, T.-R.; Lin, S.-C.; Hsu, C.-S.; Zhu, Y.; Chu, Y.-C.; Chen, T.L.; Lee, J.-F.; Chen, H.M. In situ identifying the dynamic structure behind activity of atomically dispersed platinum catalyst toward hydrogen evolution reaction. Small 2021, 17, 2005713. [Google Scholar] [CrossRef]
- Pan, X.Y.; Chen, C.H.; Chang, Y.H.; Wang, D.Y.; Lee, Y.C.; Liou, C.C.; Wang, Y.X.; Hu, C.C.; Kuo, T.R. Osteoporosis risk assessment using multilayered gold-nanoparticle thin film via saldi-ms measurement. Anal. Bioanal. Chem. 2019, 411, 2793–2802. [Google Scholar] [CrossRef]
- Kuo, T.-R.; Lee, Y.-C.; Chou, H.-L.; G, S.M.; Wei, C.-Y.; Wen, C.-Y.; Chang, Y.-H.; Pan, X.-Y.; Wang, D.-Y. Plasmon-enhanced hydrogen evolution on specific facet of silver nanocrystals. Chem. Mater. 2019, 31, 3722–3728. [Google Scholar] [CrossRef]
- Yougbare, S.; Mutalik, C.; Chung, P.F.; Krisnawati, D.I.; Rinawati, F.; Irawan, H.; Kristanto, H.; Kuo, T.R. Gold nanorod-decorated metallic MoS2 nanosheets for synergistic photothermal and photodynamic antibacterial therapy. Nanomaterials 2021, 11, 3064. [Google Scholar] [CrossRef]
- Yougbare, S.; Mutalik, C.; Okoro, G.; Lin, I.H.; Krisnawati, D.I.; Jazidie, A.; Nuh, M.; Chang, C.C.; Kuo, T.R. Emerging trends in nanomaterials for antibacterial applications. Int. J. Nanomed. 2021, 16, 5831–5867. [Google Scholar] [CrossRef]
- Yougbare, S.; Mutalik, C.; Krisnawati, D.I.; Kristanto, H.; Jazidie, A.; Nuh, M.; Cheng, T.M.; Kuo, T.R. Nanomaterials for the photothermal killing of bacteria. Nanomaterials 2020, 10, 1123. [Google Scholar] [CrossRef]
- Chang, T.-W.; Ko, H.; Huang, W.-S.; Chiu, Y.-C.; Yang, L.-X.; Chia, Z.-C.; Chin, Y.-C.; Chen, Y.-J.; Tsai, Y.-T.; Hsu, C.-W.; et al. Tannic acid-induced interfacial ligand-to-metal charge transfer and the phase transformation of Fe3O4 nanoparticles for the photothermal bacteria destruction. Chem. Eng. J. 2022, 428, 131237. [Google Scholar] [CrossRef]
- Tan, S.H.; Yougbare, S.; Tao, H.Y.; Chang, C.C.; Kuo, T.R. Plasmonic gold nanoisland film for bacterial theranostics. Nanomaterials 2021, 11, 3139. [Google Scholar] [CrossRef]
- Mutalik, C.; Wang, D.Y.; Krisnawati, D.I.; Jazidie, A.; Yougbare, S.; Kuo, T.R. Light-activated heterostructured nanomaterials for antibacterial applications. Nanomaterials 2020, 10, 643. [Google Scholar] [CrossRef] [PubMed]
- Mutalik, C.; Hsiao, Y.-C.; Chang, Y.-H.; Krisnawati, D.I.; Alimansur, M.; Jazidie, A.; Nuh, M.; Chang, C.-C.; Wang, D.-Y.; Kuo, T.-R. High uv-vis-nir light-induced antibacterial activity by heterostructured TiO2-FeS2 nanocomposites. Int. J. Nanomed. 2020, 15, 8911. [Google Scholar] [CrossRef] [PubMed]
- Chin, Y.-C.; Yang, L.-X.; Hsu, F.-T.; Hsu, C.-W.; Chang, T.-W.; Chen, H.-Y.; Chen, L.Y.-C.; Chia, Z.C.; Hung, C.-H.; Su, W.-C.; et al. Iron oxide@chlorophyll clustered nanoparticles eliminate bladder cancer by photodynamic immunotherapy-initiated ferroptosis and immunostimulation. J. Nanobiotechnol. 2022, 20, 373. [Google Scholar] [CrossRef]
- Yougbare, S.; Chou, H.L.; Yang, C.H.; Krisnawati, D.I.; Jazidie, A.; Nuh, M.; Kuo, T.R. Facet-dependent gold nanocrystals for effective photothermal killing of bacteria. J. Hazard. Mater. 2021, 407, 124617. [Google Scholar] [CrossRef]
- Mutalik, C.; Krisnawati, D.I.; Patil, S.B.; Khafid, M.; Atmojo, D.S.; Santoso, P.; Lu, S.C.; Wang, D.Y.; Kuo, S.R. Phase-dependent MoS2 nanoflowers for light-driven antibacterial application. ACS Sustain. Chem. Eng. 2021, 9, 7904–7912. [Google Scholar] [CrossRef]
- Mutalik, C.; Okoro, G.; Krisnawati, D.I.; Jazidie, A.; Rahmawati, E.Q.; Rahayu, D.; Hsu, W.T.; Kuo, T.R. Copper sulfide with morphology-dependent photodynamic and photothermal antibacterial activities. J. Colloid Interface Sci. 2022, 607, 1825–1835. [Google Scholar] [CrossRef]
- Luo, L.-J.; Lin, T.-Y.; Yao, C.-H.; Kuo, P.-Y.; Matsusaki, M.; Harroun, S.G.; Huang, C.-C.; Lai, J.-Y. Dual-functional gelatin-capped silver nanoparticles for antibacterial and antiangiogenic treatment of bacterial keratitis. J. Colloid Interface Sci. 2019, 536, 112–126. [Google Scholar] [CrossRef]
- Yougbare, S.; Chang, T.-K.; Tan, S.-H.; Kuo, J.-C.; Hsu, P.-H.; Su, C.-Y.; Kuo, T.-R. Antimicrobial gold nanoclusters: Recent developments and future perspectives. Int. J. Mol. Sci. 2019, 20, 2924. [Google Scholar] [CrossRef]
- Cheng, T.M.; Chu, H.L.; Lee, Y.C.; Wang, D.Y.; Chang, C.C.; Chung, K.L.; Yen, H.C.; Hsiao, C.W.; Pan, X.Y.; Kuo, T.R.; et al. Quantitative analysis of glucose metabolic cleavage in glucose transporters overexpressed cancer cells by target-specific fluorescent gold nanoclusters. Anal. Chem. 2018, 90, 3974–3980. [Google Scholar] [CrossRef]
- Kaur, N.; Aditya, R.N.; Singh, A.; Kuo, T.R. Biomedical applications for gold nanoclusters: Recent developments and future perspectives. Nanoscale Res. Lett. 2018, 13, 302. [Google Scholar] [CrossRef] [PubMed]
- Zheng, K.; Setyawati, M.I.; Leong, D.T.; Xie, J. Observing antimicrobial process with traceable gold nanoclusters. Nano Res. 2021, 14, 1026–1033. [Google Scholar] [CrossRef]
- Wang, Y.X.; Malkmes, M.J.; Jiang, C.; Wang, P.; Zhu, L.Y.; Zhang, H.M.; Zhang, Y.H.; Huang, H.; Jiang, L. Antibacterial mechanism and transcriptome analysis of ultra-small gold nanoclusters as an alternative of harmful antibiotics against gram-negative bacteria. J. Hazard. Mater. 2021, 416, 126236. [Google Scholar] [CrossRef]
- Wang, C.-H.; Mutalik, C.; Yougbaré, S.; Teng, N.-C.; Kuo, T.-R. Calcium phosphate nanoclusters for the repair of tooth enamel erosion. Nanomaterials 2022, 12, 1997. [Google Scholar] [CrossRef] [PubMed]
- Mei, L.; Teng, Z.; Zhu, G.Z.; Liu, Y.J.; Zhang, F.W.; Zhang, J.L.; Li, Y.; Guan, Y.G.; Luo, Y.G.; Chen, X.G.; et al. Silver nanocluster-embedded zein films as antimicrobial coating materials for food packaging. ACS Appl. Mater. Interfaces 2017, 9, 35297–35304. [Google Scholar] [CrossRef]
- Rehman, M.A.U.; Ferraris, S.; Goldmann, W.H.; Perero, S.; Bastan, F.E.; Nawaz, Q.; di Confiengo, G.G.; Ferraris, M.; Boccaccini, A.R. Antibacterial and bioactive coatings based on radio frequency Co-sputtering of silver nanocluster-silica coatings on peek/bioactive glass layers obtained by electrophoretic deposition. ACS Appl. Mater. Interfaces 2017, 9, 32489–32497. [Google Scholar] [CrossRef]
- Ferraris, M.; Perero, S.; Ferraris, S.; Miola, M.; Verne, E.; Skoglund, S.; Blomberg, E.; Wallinder, I.O. Antibacterial silver nanocluster/silica composite coatings on stainless steel. Appl. Surf. Sci. 2017, 396, 1546–1555. [Google Scholar] [CrossRef]
- Ferraris, M.; Perero, S.; Miola, M.; Ferraris, S.; Verne, E.; Morgiel, J. Silver nanocluster-silica composite coatings with antibacterial properties. Mater. Chem. Phys. 2010, 120, 123–126. [Google Scholar] [CrossRef]
- Hsu, I.L.; Yeh, F.H.; Chin, Y.-C.; Cheung, C.I.; Chia, Z.C.; Yang, L.-X.; Chen, Y.-J.; Cheng, T.-Y.; Wu, S.-P.; Tsai, P.-J.; et al. Multiplex antibacterial processes and risk in resistant phenotype by high oxidation-state nanoparticles: New killing process and mechanism investigations. Chem. Eng. J. 2021, 409, 128266. [Google Scholar] [CrossRef]
- Chang, T.-K.; Cheng, T.-M.; Chu, H.-L.; Tan, S.-H.; Kuo, J.-C.; Hsu, P.-H.; Su, C.-Y.; Chen, H.-M.; Lee, C.-M.; Kuo, T.-R. Metabolic mechanism investigation of antibacterial active cysteine-conjugated gold nanoclusters in escherichia coli. ACS Sustain. Chem. Eng. 2019, 7, 15479–15486. [Google Scholar] [CrossRef]
- Zheng, K.; Setyawati, M.I.; Leong, D.T.; Xie, J. Antimicrobial gold nanoclusters. ACS Nano 2017, 11, 6904–6910. [Google Scholar] [CrossRef] [PubMed]
- Wang, S.; Wang, Y.; Peng, Y.; Yang, X. Exploring the antibacteria performance of multicolor Ag, Au, and Cu nanoclusters. ACS Appl. Mater. Interfaces 2019, 11, 8461–8469. [Google Scholar] [CrossRef] [PubMed]
- Di Masi, A.; De Simone, G.; Ciaccio, C.; D’Orso, S.; Coletta, M.; Ascenzi, P. Haptoglobin: From hemoglobin scavenging to human health. Mol. Asp. Med. 2020, 73, 100851. [Google Scholar] [CrossRef] [PubMed]
- Zhao, X.; Zhou, J.; Du, G.; Chen, J. Recent advances in the microbial synthesis of hemoglobin. Trends Biotechnol. 2021, 39, 286–297. [Google Scholar] [CrossRef] [PubMed]
- Buehler, P.W.; Humar, R.; Schaer, D.J. Haptoglobin therapeutics and compartmentalization of cell-free hemoglobin toxicity. Trends Mol. Med. 2020, 26, 683–697. [Google Scholar] [CrossRef] [PubMed]
- Shamsipur, M.; Molaabasi, F.; Sarparast, M.; Roshani, E.; Vaezi, Z.; Alipour, M.; Molaei, K.; Naderi-Manesh, H.; Hosseinkhani, S. Photoluminescence mechanisms of dual-emission fluorescent silver nanoclusters fabricated by human hemoglobin template: From oxidation-and aggregation-induced emission enhancement to targeted drug delivery and cell imaging. ACS Sustain. Chem. Eng. 2018, 6, 11123–11137. [Google Scholar] [CrossRef]
- Shang, L.; Dong, S.; Nienhaus, G.U. Ultra-small fluorescent metal nanoclusters: Synthesis and biological applications. Nano Today 2011, 6, 401–418. [Google Scholar] [CrossRef]
- Ungor, D.; Horváth, K.; Dékány, I.; Csapó, E. Red-emitting gold nanoclusters for rapid fluorescence sensing of tryptophan metabolites. Sens. Actuators B Chem. 2019, 288, 728–733. [Google Scholar] [CrossRef]
- del Caño, R.; Mateus, L.; Sánchez-Obrero, G.; Sevilla, J.M.; Madueño, R.; Blázquez, M.; Pineda, T. Hemoglobin bioconjugates with surface-protected gold nanoparticles in aqueous media: The stability depends on solution pH and protein properties. J. Colloid Interface Sci. 2017, 505, 1165–1171. [Google Scholar] [CrossRef] [PubMed]
- Spratt, B.G.; Hedge, P.J.; Heesen, S.T.; Edelman, A.; Broomesmith, J.K. Kanamycin-resistant vectors that are analogs of plasmids puc8, puc9, pembl8 and pembl9. Gene 1986, 41, 337–342. [Google Scholar] [CrossRef]
- Schaer, C.A.; Jeger, V.; Gentinetta, T.; Spahn, D.R.; Vallelian, F.; Rudiger, A.; Schaer, D.J. Haptoglobin treatment prevents cell-free hemoglobin exacerbated mortality in experimental rat sepsis. Intensive Care Med. Exp. 2021, 9, 22. [Google Scholar] [CrossRef] [PubMed]
- Kuo, J.C.; Tan, S.H.; Hsiao, Y.C.; Mutalik, C.; Chen, H.M.; Yougbare, S.; Kuo, T.R. Unveiling the antibacterial mechanism of gold nanoclusters via in situ transmission electron microscopy. ACS Sustain. Chem. Eng. 2022, 10, 464–471. [Google Scholar] [CrossRef]

Publisher’s Note: MDPI stays neutral with regard to jurisdictional claims in published maps and institutional affiliations. |
© 2022 by the authors. Licensee MDPI, Basel, Switzerland. This article is an open access article distributed under the terms and conditions of the Creative Commons Attribution (CC BY) license (https://creativecommons.org/licenses/by/4.0/).
Share and Cite
Chu, H.-Y.; Chen, L.-C.; Kuo, T.-R.; Shih, C.-C.; Yougbaré, S.; Chen, Y.-H.; Cheng, T.-M. Haptoglobin-Conjugated Gold Nanoclusters as a Nanoantibiotic to Combat Bacteremia. Nanomaterials 2022, 12, 3596. https://doi.org/10.3390/nano12203596
Chu H-Y, Chen L-C, Kuo T-R, Shih C-C, Yougbaré S, Chen Y-H, Cheng T-M. Haptoglobin-Conjugated Gold Nanoclusters as a Nanoantibiotic to Combat Bacteremia. Nanomaterials. 2022; 12(20):3596. https://doi.org/10.3390/nano12203596
Chicago/Turabian StyleChu, Hsiu-Yi, Lung-Ching Chen, Tsung-Rong Kuo, Chun-Che Shih, Sibidou Yougbaré, Yu-Han Chen, and Tsai-Mu Cheng. 2022. "Haptoglobin-Conjugated Gold Nanoclusters as a Nanoantibiotic to Combat Bacteremia" Nanomaterials 12, no. 20: 3596. https://doi.org/10.3390/nano12203596
APA StyleChu, H.-Y., Chen, L.-C., Kuo, T.-R., Shih, C.-C., Yougbaré, S., Chen, Y.-H., & Cheng, T.-M. (2022). Haptoglobin-Conjugated Gold Nanoclusters as a Nanoantibiotic to Combat Bacteremia. Nanomaterials, 12(20), 3596. https://doi.org/10.3390/nano12203596

